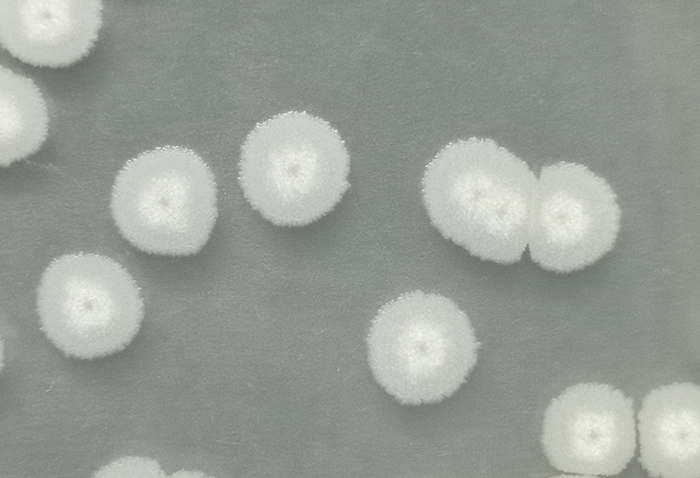

-
1
Bacillus subtilis
Product description
Bacillus subtilis is a kind of bacillus widely distributed in soil and rotten organic matter. It can enter the spore dormancy period under harsh conditions such as lack of nutrients and other unfavorable conditions, and form a bacterium with strong resistance to stress. It can survive in extreme environment such as high temperature, acid and alkali.
Product specification and property
Powder product property:Light yellow powder
Powder product specification: 20 billion/g、50 billion/g、100 billion/g、200 billion/g、500 billion/g
Liquid product:Light brown or reddish brown liquid
Liquid product specification:10 billion/ml、20 billion/ml
Product Function
Agricultural planting
1、 Bacillus subtilis competes with pathogens for nutrients around plants by successfully colonizing into the rhizosphere, body surface or within the body. It will secrete antibacterial substances to inhibit the growth of pathogens. At the same time, it induces the plant defense system to resist the invasion of pathogenic bacteria, so as to achieve the purpose of biological control.
2、 Bacillus subtilis can mainly inhibit rice sheath blight, rice blast, wheat sheath blight, bean root rot, gray mold, powdery mildew, downy mildew and other plant diseases caused by filamentous fungi and other plant pathogens.
Area of application
Biological organic fertilizer fermentation, production or preparation of organic fertilizer, etc.
Usage and dosage (100 billion /g powder as an example)
1、 Directly add water to dilute this product by 500 ~1000times, mix it evenly and then spray on the leaves or soil irrigation. It is recommended to apply 5 ~ 10g/mu/666.7m2, once every 7 days, 3 ~4times in a row;
2、 Organic fertilizer fermentation: the recommended addition amount is300~500 g/ton, of which main material: auxiliary material = 5: 1 ~3; 1, mix this product with main material and auxiliary material evenly according to the requirements, and pile up no less than 4 cubic meters at a time. The ambient temperature is above 15 °C. When the pile temperature rises to 60℃, begin to turn the pile once a day (if the pile temperature exceeds 65℃, then shall turn the pile again till the temperature fall). The decomposing will be completed when the pile temperature is reduced and the material is loose, and there will be no material odor.
3、 Preparation of organic fertilizer: Mix 1~2kg Bacillus subtilis with farmyard manure, chemical fertilizer or appropriate amount of fine soil evenly and use it as base fertilizer or top dressing. Hole fertilizing or ditch fertilizing can be used for transplanting crops.
4、 Seedbed: Use 5~10g of this product per standard seedbed. Mix well with the seedbed soil and sow.
5、 Potted flowers: 1~2g of this product can be used per kg of potted soil. Add water to dissolve and water.
Animal feed
1、 Bacillus subtilis grows fast and can produce subtilisin, polymyxin, gramicidin and other active substances, which have a significant inhibitory effect on harmful bacteria in the intestinal tract of animals.
2、 Bacillus subtilis can rapidly consume free oxygen in the intestinal tract of animals, causing intestinal hypoxia and promoting the growth of beneficial anaerobic bacteria in the intestinal tract. Meanwhile indirectly inhibit the growth of other pathogenic bacteria.
3、 In aquaculture, bacillus subtilis will decompose residual bait, feces, dead grass, dead algae and other organic matter in the pond. Reducing suspended organic matter in the water body and improving the transparency of the water body.
4、 Self-synthesis of amylase, protease, lipase, cellulase and other enzymes to promote feed conversion rate.
5、 Synthesize a variety of B vitamins and improve animal immunity.
6、 Safe, green, non-toxic, pollution-free, and without side effects.
Area of application
Farmed animals
Usage and dosage (take 20 billion /g model as an example)
|
Animal species |
Dosage (g/ ton feed) |
|
piglets |
200--300 |
|
Medium and large pigs |
100--200 |
|
Egg-laying poultry |
150--200 |
|
Meat poultry |
150--200 |
|
Ruminant animals |
200--300 |
|
Aquatic animals |
300--500 |
|
Animal drinking water will choose water soluble products: according to the ratio of 1:250 ~ 1:500 (for example 1 ton of water needs 2-4kg) |
|
Aquaculture usage and dosage (take 20 billion /g model as an example)
|
Item |
Dosage |
Usage |
|
Water purification |
20-30g/666.67㎡/mu |
Dilute with water and pour over the whole pool |
|
Reduce ammonia nitrogen |
30g/666.67㎡/mu |
Dilute with water and pour over the whole pool |
|
Inhibit moss |
50-60g/666.67㎡/mu |
After diluting with water, sprinkle the whole pool together with sodium humate etc. |
Caution
1、 Do not use it together with fungicides, antibiotics or disinfectants
2、 Each time after opening the bag or bucket, please tie the bag mouth or tighten the bucket cover if not used up. So as to avoid the inactivation of active ingredients.
Packing and storage
1. Packaging: 2kg/ bag (bucket); 20kg/ bag (bucket)
2. This product is an active biological agent. During transportation and storage, it should be protected from light, keep low temperature, dry and ventilated.
3. The shelf life of this product is 12 months in the cool and dry environment.
Related products:
Hits:8531 Entry time:2023-01-30 13:53:48【Print this page】【return】